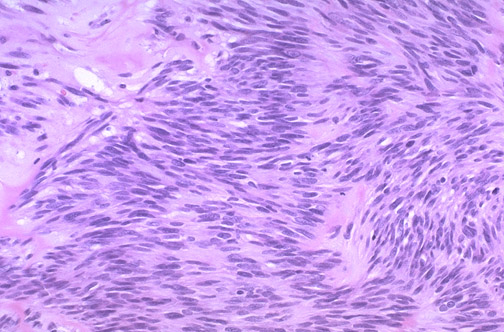

| The bundles of spindle cells are typical for a gastrointestinal stromal tumor (GIST). The biologic potential of these tumors is notoriously difficult to evaluate. The most important features are mitotic count, size, and cellularity. This tumor, because of its large size and increased cellularity, but relative lack of mitotic activity, has been classified as a stromal tumor of uncertain malignant potential, or STUMP. |
![]() |